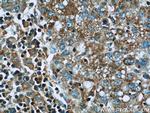
IGF2R Antibody in Immunohistochemistry (Paraffin) (IHC (P))

Search
Proteintech
IGF2R Polyclonal Antibody
{{$productOrderCtrl.translations['antibody.pdp.commerceCard.promotion.promotions']}}
{{$productOrderCtrl.translations['antibody.pdp.commerceCard.promotion.viewpromo']}}
{{$productOrderCtrl.translations['antibody.pdp.commerceCard.promotion.promocode']}}: {{promo.promoCode}} {{promo.promoTitle}} {{promo.promoDescription}}. {{$productOrderCtrl.translations['antibody.pdp.commerceCard.promotion.learnmore']}}
产品信息
20253-1-AP
种属反应
已发表种属
宿主/亚型
分类
类型
抗原
偶联物
形式
浓度
规格
纯化类型
保存液
内含物
保存条件
运输条件
产品详细信息
The antibody is specific to IGF2R.
靶标信息
Lysosomal enzymes containing one or two mannose 6-phosphate (man6P) moieties are moved about in the cell by two distinct but interconnected cycles by means of approximately 300 kDa cation independent mannose 6-phospate receptors (CI-MPR). The biosynthetic cycle refers to the MPR transport of newly synthesized lysosomal enzymes from the trans Golgi network to late endosomes or early lysosomes. The endocytic cycle transports extracellular lysosomal enzymes from the plasma membrane via clathrin-coated vesicles to early endosomes. The entire pool of MPRs cycles between these cellular compartments every 3 hours. The steady state distribution of MPR's is predominantly within late endosomes, fewer in the trans Golgi network and approximately 10 % at cell surface. In addition to its man6P binding activity, the MPR contains a separate binding site for the type II insulin-like growth factor and is capable of binding both man6P and IGF-II simultaneously. An approximately 240 kDa soluble, truncated form, representing the extracellular domain of the protein, has also been found circulating in serum and is capable of binding both ligands.
仅用于科研。不用于诊断过程。未经明确授权不得转售。
生物信息学
蛋白别名: 300 kDa mannose 6-phosphate receptor; Cation-independent mannose-6-phosphate receptor; CD222; CI Man-6-P receptor; IGF-II receptor; Insulin-like growth factor 2 receptor; Insulin-like growth factor II receptor; M6P/IGF2 receptor; M6P/IGF2R; mannose 6-phosphate/insulin-like growth factor-II receptor; MPR 300; unnamed protein product
基因别名: CD222; CI-M6PR; CIMPR; IGF2R; M6P-R; M6P/IGF2R; MPR 300; MPR1; MPR300; MPRI
UniProt ID: (Human) P11717
Entrez Gene ID: (Human) 3482